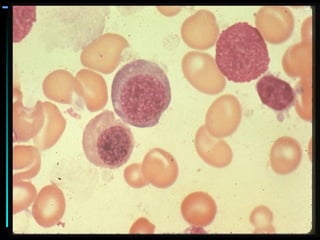
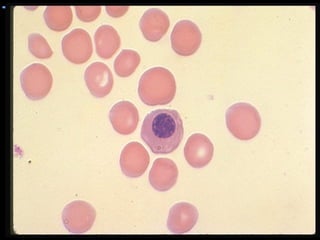
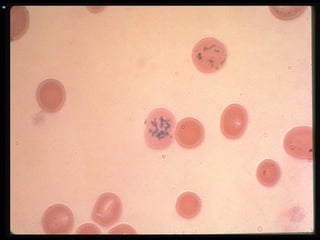
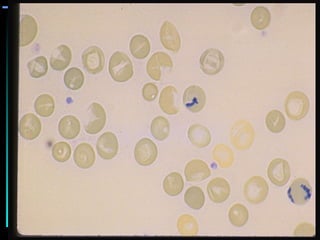

This document discusses hematology and hematopoiesis. It summarizes that hematology is the study of blood and its components, which provide nutrients, remove waste, and protect the body. Hematopoiesis, or blood cell formation, occurs exclusively in the bone marrow and involves pluripotent stem cells differentiating into various blood cell types through cytokine influences. In particular, it focuses on erythropoiesis, the formation of red blood cells, which involves erythropoietin signaling proliferation and differentiation of red blood cell precursors over 5-7 days from pronormoblast to reticulocyte to mature red blood cell.